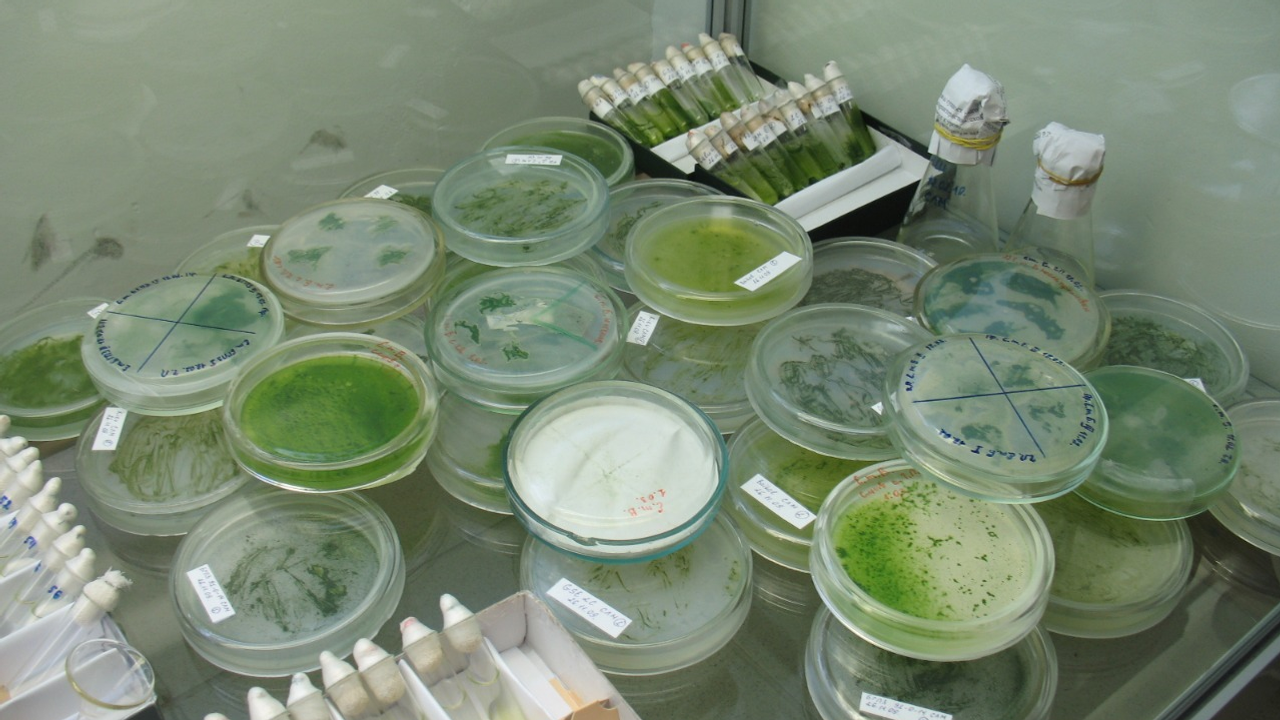

В начале недели в БГПУ им. М.Акмуллы прошла пленарная часть выездного заседания совета по биологии Федерального учебно-методического объединения «Биологические науки».
Генеральная тема заседания – «Особенности организации подготовки биологов в университетах России в связи с изменениями нормативной базы высшего образования».
На заседание прибыли председатели и члены Советов ФУМО из МГУ имени М.В. Ломоносова, УрФУ им. Б.Н. Ельцина, СФУ, НИЯУ МИФИ и других вузов России. География участников заседания обширна: от Владивостока до Архангельска, Нижнего Новгорода и Волгограда.
В программе заседания были рассмотрены проблемы и перспективы организации учебного процесса в соответствии с требованиями Федерального государственного образовательного и профессиональных стандартов, вопросы формирования нового перечня направлений подготовки и специальностей высшего образования, реализации сетевых образовательных программ, подготовки специалистов в области биомедицины, развития высшей школы и фундаментального биологического образования.
Акмуллинский университет выбран в качестве базы проведения заседания ФУМО не случайно. Несмотря на педагогический профиль вуза, здесь создана сильная естественно-научная школа.
Почти три десятилетия в Башкирском государственном педагогическом университете им. М. Акмуллы работает альгологическая школа, основанная доктором биологических наук, профессором Рустэмом Кабировым. Альгологи университета изучают биоразнообразие, экологию, современную таксономию и систематику наземных водорослей и цианобактерий.
В лаборатории молекулярной систематики фототрофных микроорганизмов им. Л.С. Хайбуллиной БГПУ им. М. Акмуллы собрана уникальная коллекция водорослей и цианобактерий, насчитывающая более тысячи штаммов, полученных на территории Башкортостана, а также из пустынных каньонов США, вулканических почв Камчатки, из Антарктики и других уголков планеты. Проект Акмуллинского университета по альгологии включен в перечень проектов Евразийского научно-образовательного центра.
Кроме того, БГПУ им. М. Акмуллы является единственным педагогическим университетом в России, в котором ведется подготовка специалистов-генетиков по программам классического биологического образования. Кафедра генетики была основана в университете в 1999 году, и с тех пор в вузе ведется активная научная работа в этом направлении.
Заместитель председателя ФУМО «Биологические науки», зам. декана биологического факультета МГУ им. М.В. Ломоносова Александр Ким отметил, что кафедра генетики и химии БГПУ им.Акмулллы – одна из ведущих России. Она выпускает фундаментальных ученых, которые работают сейчас в Москве, Санкт-Петербурге и за границей, в системе Российской Академии Наук и медицинских учреждениях.
Кроме этого, для школьников, педагогов и родителей в университете разработан просветительский проект «Образовательная генетика». Он направлен на популяризацию знаний по генетике и привлечение интереса талантливой молодежи к генетическим технологиям.
Проект подразумевает разработку образовательных программ и учебных модулей для общеобразовательных школ и повышение компетентности учителей биологии и педагогов дополнительного образования в области генетических технологий.
Мероприятия выездного заседания совета ФУМО по биологии проходили с 17 по 21 мая на базе БГПУ им.М.Акмуллы и БГМУ, а также в санатории «Янган-тау».